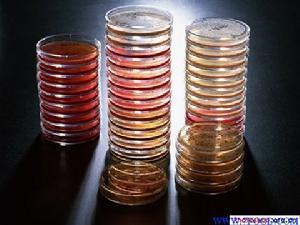
平板培養基

名詞解釋
‍培養平板培養基(culture plate)是被用於獲得微生物純培養的最常用的固體培養基形式,它是冷卻凝固後的固體培養基在無菌培養皿中形成的培養基固體平面,常被簡稱為培養平板(plate)。也叫平面培養基、平皿培養基。
平板培養基常用於單孢分離,測定菌絲生長速度,觀察菌落的形態,拮抗實驗,測定接種空間雜菌數。
製作方法
平皿培養基
平皿培養基① 將培養皿洗淨、乾燥,使各培養皿蓋方向一致,用牛皮紙包好,或放入特製鐵罐內,註明皿蓋的方向。高壓滅菌或乾燥滅菌後備用。
② 取剛滅菌後尚未凝固的培養基置於無菌箱或超淨工作檯內,略打開滅菌過的培養皿蓋(露一小縫),倒入培養基(厚度為0.5cm),封蓋、冷凝,倒置備用。
